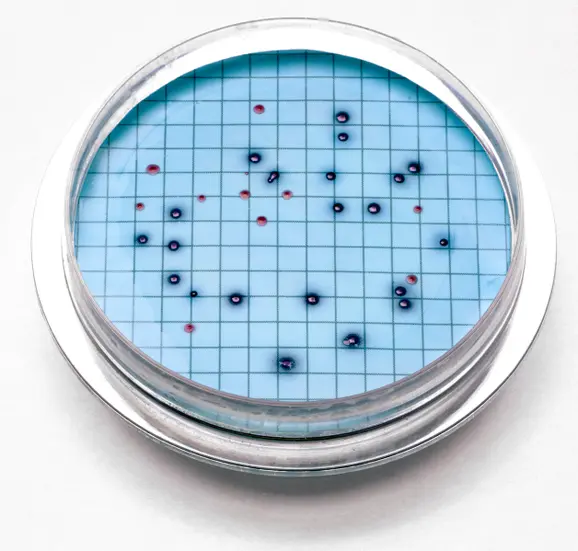

m-ColiBlue24® Broth, Plastic Ampules, 50/pk
1,000.00৳
Product Number: 2608450
⛟ Stock products delivery time 1-3 working days. 🔥
✈ Out-of-stock products delivery time 10-20 working days. 🚀
Benefits
Simultaneously detect total coliforms and E. coli – in just 24 hours.
Hach’s m-ColiBlue24 Broth simultaneously detects and identifies both total coliforms and Escherichia coli (E. coli). Incubation time is 24 hours for complete enumeration. There is no confirmation step.
Easily read and interpret results.
m-ColiBlue24 makes it easy to differentiate between coliforms and E. coli – E. coli are blue; other coliforms are red; total coliforms are the sum of the two. It’s that simple.
Save money by eliminating special equipment and UV lamps.
m-ColiBlue24 requires no fluorescent lamps or color comparators—interpretation of the results is through easy, visual identification.
Minimize background growth of non-coliform bacteria, reduce false positives and false negatives, plus get superior sensitivity down to 1 CFU/100 mL.
Enumerate test results directly with m-ColiBlue24 Broth. m-ColiBlue24 is much more accurate and precise than statistical-based tests such as Most Probable Number (MPN) and Multiple Tube Fermentation (MTF).
Conduct emergency testing and routine monitoring.
m-ColiBlue24 is the best value for an EPA-approved, 24-hour media for enumeration of total coliforms and E. coli.
Shipping Information
Out Of Dhaka: 1–3 working days for most locations within Bangladesh and cost only ৳120 TAKA.
Know more details.
Return Policy
You may return items purchased from Meter BD Shop within 7 days of receiving the product.
To be eligible for a return, the product must meet the following conditions:
1. Unused, 2. In the original packaging & 3. Proof of purchase.
Reviews
There are no reviews yet.